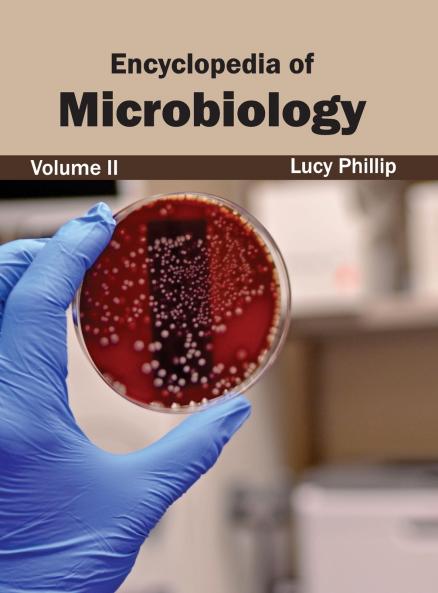
Encyclopedia of Microbiology
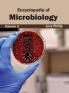
Encyclopedia of Microbiology

English
Hardback
₹14368
(All inclusive*)
Delivery Options
Please enter pincode to check delivery time.
*COD & Shipping Charges may apply on certain items.
Review final details at checkout.
Looking to place a bulk order? SUBMIT DETAILS
Delivery Options
Please enter pincode to check delivery time.
*COD & Shipping Charges may apply on certain items.
Review final details at checkout.
About The Book
Description
Author
This book attempts to understand the science of microbiology. The current research and data available in this field are discussed and the ramifications of advancements in this arena are also included. The various branches that microbiology overlaps with or that shoot out from it are glanced at with research and future opportunities for progress. Researchers and students of this field will be assisted by this book. It will help them in increasing their expertise by helping them keep up with the rapid changes in microbiology.
Details
ISBN 13
9781632392701
Publication Date
-04-03-2015
Pages
-198
Weight
-632 grams
Dimensions
-216x280x12.7 mm